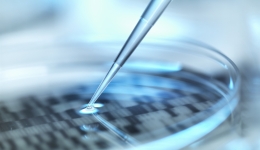

跑步如何預防應力性骨折
- 2022-06-16 10:33
- 作者:鄒榮琪
- 來源:人民網-人民日報海外版
應力性骨折,又稱疲勞性骨折或積累性勞損,是一種過度使用造成的骨骼損傷。當肌肉過度使用產生疲勞后,不能及時吸收反復碰撞所產生的震動,將應力傳導至骨骼,可引起小的骨裂或骨折,并伴有局部腫脹和疼痛。出現應力性骨折后,約20%的人運動會受到影響。
造成應力性骨折的風險因素主要包括能量攝入不足、骨質受到破壞、體內缺乏維生素D、跑步內容安排不合理等,其他影響因素還包括跑步者的年齡、身高、體重等。
針對應力性骨折產生的風險因素,積極采取以下措施尤為重要。
均衡膳食,補充足夠的熱量。長距離跑步會消耗大量能量,建議在跑步前2—4小時補充充足的富含碳水化合物的谷類、薯類食物和運動飲料(含碳水化合物和電解質),以保證肝糖原和肌糖原儲備。在高強度運動結束后的90分鐘里,糖原的合成速度較快,此時需補充適量碳水化合物,以促進糖原的恢復。
補充維生素D。維生素D是維持骨骼健康所必需的物質,它可以促進人體對鈣的吸收,保護骨骼。在日常生活中,維生素D主要由人體皮膚經紫外線照射后合成,少部分從食物或補充品中攝入。長距離跑步運動后,單次飲食補充維生素D有時難以滿足機體的需求,通常建議在跑步后每天補充400IU—800IU(國際單位)維生素D。
合理安排跑步內容。建議跑步運動前做5—10分鐘的熱身和肌肉拉伸,并將力量訓練納入日常鍛煉中,尤其要加強應力性骨折好發部位足部和小腿的肌肉力量練習。建議每周安排兩次肌肉耐力和力量練習,每個主要肌肉群應該訓練2—4組,重復8—12次,組間休息2—3分鐘。此外,每周可安排2次交叉訓練,訓練內容可以選擇游泳、騎行等,交叉訓練是很多世界頂級跑步選手預防跑步損傷的有效手段。如果長距離跑步后,肌肉持續出現酸痛,后續則需要減少運動量或休息,使身體逐漸適應跑步的節奏。
發現有應力性骨折癥狀,應減少運動量或停止鍛煉。不建議盲目使用止痛藥,尤其是非甾體抗炎藥,如布洛芬等,除非醫生建議使用。出現應力性骨折癥狀時,建議采取用“R.I.C.E.”方法處理:R(Rest)休息、I(Ice)冰敷、C(Compress)加壓包扎和E(Elevation)抬高患肢。通常在受傷部位敷上冰袋,每次15分鐘,每次間隔2—3小時,注意不要把冰直接敷在受傷的地方,以免引起局部皮膚凍傷;受傷部位加壓包扎不要太緊,否則會導致血液循環障礙;把患肢抬高到高于心臟位置,可幫助減少受傷部位的腫脹。應力性骨折分為低風險和高風險兩種,低風險應力骨折可以通過減少活動或其他物理治療方法促進骨折愈合,但對于高風險應力性骨折,應積極預約骨科醫生進行診治。
(作者為國家體育總局運動醫學研究所運動創傷防治與康復研究中心副主任)
《中國醫藥報》社版權所有,未經許可不得轉載使用。
(責任編輯:王哲涵)
右鍵點擊另存二維碼!
-
為你推薦